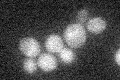
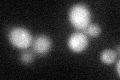
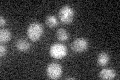

View description
Component of the hexameric MCM complex, which is important for priming origins of DNA replication in G1 and becomes an active ATP-dependent helicase that promotes DNA melting and elongation when activated by Cdc7p-Dbf4p in S-phase
Localization:
Intensity:
Fold change:
Significance:
-
C’ GFP library in SD
below threshold14.74 -
N' NOP1pr-GFP in SD

nucleus36.4851 -
N' TEF2pr-mCherry in SD

nucleus35.715 -
N' NATIVEpr-GFP in SD

nucleus32.486 -
N' TEF2pr-VC and Cyto-VN in SD

#N/A0 -
C’ GFP library in SD+DTT
cytosol17.491.18No -
C’ GFP library in SD+H2O2

cytosol14.240.96No -
C’ GFP library in Starvation Media
cytosol18.291.24No -
C’ GFP library on the background of Pup2-DaMP

below threshold -
C’ GFP library on the background of CCT mutant

below threshold15.52881.05325No
